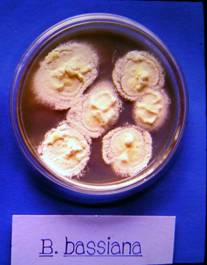

เชื้อราขาว (white muscardine) |
||||||||||||
เชื้อราขาว B. bassiana (Balsamo) Vuillemin สปอร์เป็นรูปทรงกลม ก้านชูสปอร์เป็นเส้นยาว เรียงเป็นสายเดี่ยว หรือแตกเป็นกิ่งก้านรวมกันคล้ายรูปจาน เส้นใยทรงกระบอกเส้นผ่าศูนย์กลาง 1.5-2.0 ไมครอน สีใส มีผนังกั้น การทำลายแมลงเกิดจากเชื้อราเมื่อเข้าสู่ตัวแมลงจะสร้างสารพิษ Beauvericin ทำลายเนื้อเยื่อและระบบต่างๆ ของแมลง ทำให้แมลงตายอย่างรวดเร็วเมื่อเชื้อราสร้างเส้นใยจนเต็มตัวแมลง แมลงจะนิ่งอยู่กับที่ เชื้อราก็จะสร้างเส้นใยแทงผ่านลำตัวแมลงออกมาภายนอก เพื่อสร้างสปอร์ไว้ขยายพันธุ์ต่อไป แมลงที่ตายเพราะเชื้อรา ลำตัวมักจะแห้งแข็งและมีเส้นใยและสปอร์ปกคลุมทั่วตัว เรียกลักษณะนี้ว่า มัมมี่
เพลี้ยกระโดดสีน้ำตาลที่ถูกทำลายโดยเชื้อราขาว B. bassiana (Balsamo) Vuillemin
แมลงดำหนามที่ถูกทำลายโดยเชื้อราขาว
เชื้อราขาว B. bassiana (Balsamo) Vuillemin ที่เลี้ยงบนอาหารเลี้ยงเชื้อ |